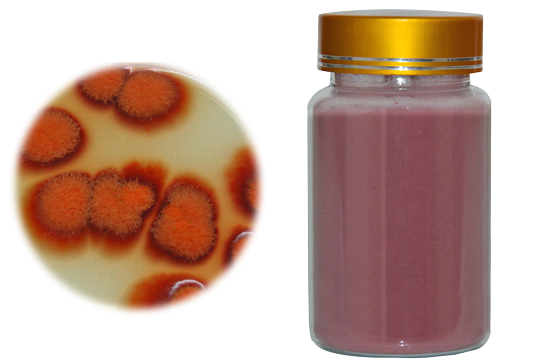

qualityherb's Updates (45)
-
7 Great Advantage Of Ginkgo Biloba Extract - A Plant Extract Manufacturer While the leaves of these trees tend to produce traditional Chinese medicines, which mainly focus on creating ginkgo plant extract manufactured from the leaves of its branches, this supplement is used to cure several health issues.This is because the Ginkgo increases blood flow and promotes dilation in the blood vessels. In such a way, blood vessels respond efficiently during circumstances of poor circulation.... [more]
-
Nutritional Value And Health Advantages of Maitake Mushroom Extract The nutritional value of Maitake Mushroom Extract is the high value of protein, fiber, zinc, vitamins, minerals, and essential amino acids with low calories. Chinese have been using this extract since ancient times, believing that mushroom helps promote good health and vitality because it contains rich health content.The mushroom of this nutrition includes lentinan, which has some adverse effects on the stomach, bowel,... [more]
-
Reduce Fat & Beating Depression - Rhodiola Rosea Extract Qualityherb is pharmaceutical industry; here you can get best quality rhodiola rosea extract It helps to reduce body fat and beneficial for beating depression We sell only best quality pure natural products. #Rhodiola_Rosea_Extract https://bit.ly/3oXHjNN [more]
-
Red Yeast Rice Powder is Beneficial for Lowering Cholesterol Red yeast rice Powder, also known as red rice, red yeast, aspergillus fungi purple monascus parasitic on the rice, the main components of lovastatin, monascus pigment, г-aminobutyric acid and unsaturated fatty acids, with "blood Blood stasis, spleen digestion, temperature and stomach "function. #Red_Yeast_Rice_Powder https://bit.ly/38T9E2a [more]
-
Best Sodium Hyaluronate Cosmetics Product for Beauty Sodium hyaluronate is the sodium salt of hyaluronic acid. It is a glycosaminoglycan and long-chain polymer of disaccharide units of Na-glucuronate-N-acetylglucosamine. #Sodium_Hyaluronate https://bit.ly/35VL7aL [more]
-
Beneficial of Horny Goat Weed Extract Horny Goat Weed Extract, also named Epimedium Sagittatum Extract, is extracted from stem and leaves of horny hoat weed, also named epimedium. Icraiin is yellow brown powder,soluble in ethanol, ethyl acetate. Icraiin insoluble in water, and insoluble in ether, benzene,chloroform. #Horny_Goat_Weed_Extract https://bit.ly/3sAIzZj [more]
-
High Quality Herb Extract Quality Herb is Good manufacture in china of herbal extrat. it is speicialize in it and can provide more than 200 kind of plant extract. #Herb_Extract https://bit.ly/3bPKYJF [more]
-
You Can Buy Top Rhodiola Rosea Extract https://bit.ly/3aufRCR
-
2021 Latest Red Yeast Rice Powder https://bit.ly/2WzE56A
-
Online Book Sodium Hyaluronate https://bit.ly/2KlP4Ok
-
How to Shop Horny Goat Weed Extract https://bit.ly/3mBL8pX
-
Are You Searching Online Latest Herb Extract https://bit.ly/3rdJRZD
-
Latest Rhodiola Rosea Extract https://bit.ly/3l5Y0Vo
-
Red Yeast Rice Powder at Lowest Price in China https://bit.ly/3p5HSWn
-
Are you Finding Sodium Hyaluronate https://bit.ly/2IabVLO